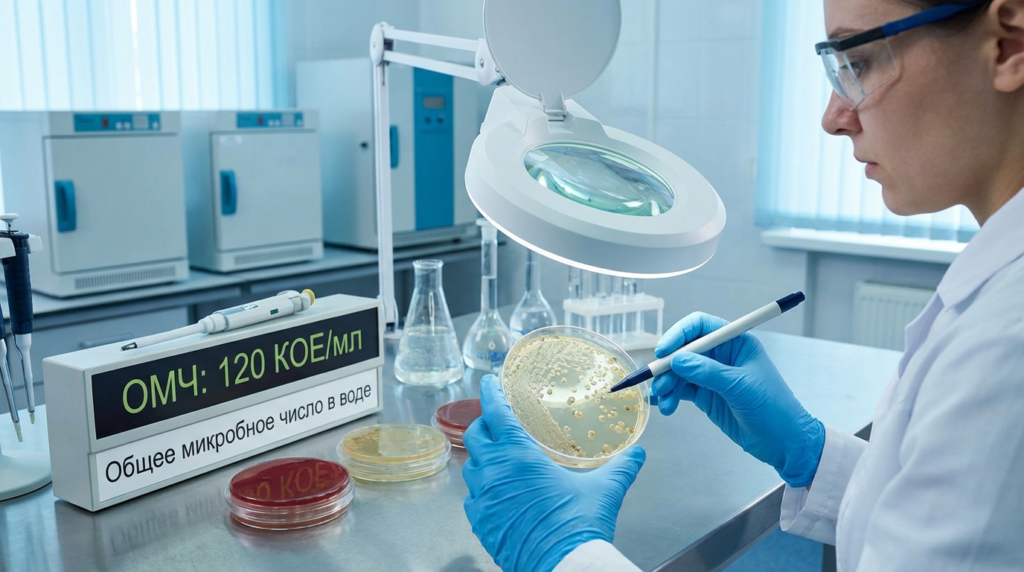

Общее микробное число в воде: определение и значение
Что такое общее микробное число (ОМЧ)?
Общее микробное число (ОМЧ) в микробиологии – это показатель, который отражает количество микроорганизмов в воде, определяемое путем культивирования при заданной температуре. ОМЧ в анализе воды проводится для контроля качества питьевой воды, пищевых продуктов и санитарного состояния различных объектов. Оно помогает выявить возможное загрязнение воды и определить эффективность водоочистных систем.
ОМЧ воды: определение и методика анализа
Общее микробное число воды – это количественная характеристика микроорганизмов, присутствующих в пробе жидкости. Основной метод определения ОМЧ заключается в инкубации образцов воды на питательной среде при температуре 37°C в течение 24 часов. После этого проводится подсчет выросших колоний микроорганизмов.
Основные этапы анализа ОМЧ воды:
- Отбор пробы воды в стерильные ёмкости, соблюдая меры предосторожности, чтобы избежать внешнего загрязнения.
- Посев образца на плотную питательную среду (чаще всего используют агар, а также другие специализированные питательные среды).
- Инкубация при температуре 37°C в течение суток, что позволяет размножиться бактериям, характерным для среды обитания человека.
- Подсчет колоний и интерпретация результатов, основанная на установленных санитарных нормативах.
ОМЧ питьевой воды: нормы и требования
ОМЧ питьевой воды – это один из ключевых показателей санитарного состояния воды, который указывает на её безопасность для потребления. Согласно санитарным нормам, допустимое значение ОМЧ в воде не должно превышать определённого количества колониеобразующих единиц (КОЕ) на 1 мл.
В разных странах установлены свои предельно допустимые нормы ОМЧ для питьевой воды:
- В России согласно СанПиН ОМЧ при 37°C не должно превышать 50 КОЕ/мл.
- В странах ЕС предельный уровень также составляет 50 КОЕ/мл.
- В США требования различаются в зависимости от типа водоснабжения и системы очистки, но в целом этот показатель остается важным критерием безопасности.
При превышении установленных нормативов питьевая вода может потребовать дополнительной очистки, а также анализа на наличие патогенных бактерий, таких как кишечная палочка (E. coli) или сальмонеллы.
ОМЧ в микробиологии и его влияние на здоровье
В микробиологии ОМЧ воды – это индикатор возможного присутствия патогенных бактерий. Хотя само по себе превышение ОМЧ не означает наличие опасных микроорганизмов, оно сигнализирует о потенциальном загрязнении воды органическими веществами, что может привести к размножению патогенов, таких как кишечная палочка (E. coli), сальмонеллы и другие.
Факторы, влияющие на повышение ОМЧ в воде:
- Загрязнение источника воды сточными водами.
- Недостаточная очистка и дезинфекция.
- Старение водопроводных систем и наличие биоплёнок.
- Высокое содержание органических веществ в воде.
- Температурные изменения, способствующие росту бактерий.
Высокий показатель ОМЧ может указывать на недостаточную дезинфекцию воды, а также на нарушение санитарных норм в системе водоснабжения.
Как снизить ОМЧ воды?
Для того чтобы снизить ОМЧ в воде и обеспечить её безопасность, используются следующие методы:
- Хлорирование воды – один из самых распространённых способов дезинфекции, уничтожающий большую часть бактерий.
- Озонирование – уничтожает микроорганизмы и улучшает органолептические свойства воды.
- Ультрафиолетовая обработка – эффективный метод для уничтожения бактерий и вирусов без использования химикатов.
- Фильтрация с применением мембранных технологий, включая обратный осмос, который способен удалять даже мельчайшие примеси и микроорганизмы.
- Кипячение воды, которое также является простым и действенным способом временного улучшения её качества.
Особенности контроля ОМЧ на предприятиях и в бытовых условиях
Контроль ОМЧ особенно важен на предприятиях, связанных с производством питьевой воды, пищевой продукции, фармацевтических препаратов и косметических средств. Регулярные лабораторные анализы позволяют предотвращать возможное загрязнение продукции и обеспечивать высокие стандарты качества.
В бытовых условиях контроль ОМЧ возможен с помощью тест-наборов, предназначенных для экспресс-анализа воды. Однако для точных данных необходимо обращаться в аккредитованные лаборатории, проводящие детальный анализ воды.
Заключение
Общее микробное число в воде – важный показатель, который отражает её микробиологическую чистоту. Контроль ОМЧ в питьевой воде необходим для предотвращения рисков заражения патогенными микроорганизмами и обеспечения санитарных норм. Регулярный анализ воды, соблюдение санитарных стандартов и применение современных методов очистки позволяют минимизировать возможные угрозы для здоровья человека.





















